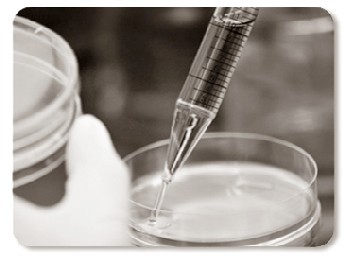

Giulio Cavalli
Attore, drammaturgo, regista e scrittore.Quarta puntata di RadioMafiopoli

15 Ott. 2008 |
Comunicato da RadioMafiopoli

8 Ott. 2008 |
Terza puntata di Radio Mafiopoli

4 Ott. 2008 |
Cronache da Bengodi: l’intervista possibile a Luisito Moderato Uolter Segretario dei Ditocratici

26 Set. 2008 |
Seconda puntata di Radio Mafiopoli

24 Set. 2008 |
1 commento |
Cronache da Bengodi: girovita sulla sicurezza

19 Set. 2008 |
1 commento |
Prima puntata di Radio Mafiopoli

17 Set. 2008 |
Come ti cucino l’Ali-bengodi alla griglia ma senza fumo

12 Set. 2008 |
Cronaca da Bengodi, profondo nord. Prima con riassunto delle puntate precedenti inesistenti.
6 Set. 2008 |